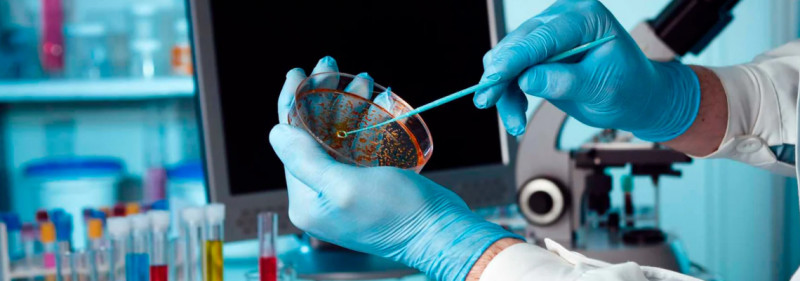
BDU-da klinik biokimya üzrə təlim proqramı

BDU-da klinik biokimya üzrə təlim proqramı
Bakı Dövlət Universitetinin (BDU) Biologiya fakültəsinin nəzdində fəaliyyət göstərən Gənc Onkogenetika Tədqiqatçılar Qrupunun təşkilatçılığı ilə 27 mart – Azərbaycan Respublikasında “Elm günü” münasibətilə təşkil olunan tədbirlər çərçivəsində klinik biokimya üzrə təlim proqramı keçirilib.
Proqram nəzəri və praktiki mərhələlərdən ibarət olub. Təlimin nəzəri hissəsində iştirakçılara klinik biokimyanın əsas prinsipləri, laborator diaqnostikada tətbiq olunan müasir metodlar, biokimyəvi göstəricilərin klinik əhəmiyyəti və analiz nəticələrinin interpretasiyası barədə məlumat verilib.
Təlimin praktiki mərhələsi “Ellab” Diaqnostika Mərkəzinin biokimyəvi laboratoriyasında təşkil olunub. Praktiki məşğələlər zamanı tələbələr müasir laborator analizatorların iş prinsipi ilə tanış olub, real nümunələr üzərində işləyərək analiz prosesinin mərhələlərini müşahidə ediblər. Tələbələrə laborator təhlükəsizlik qaydaları və keyfiyyətə nəzarət mexanizmləri barədə izahatlar verilib.
Təlim proqramının əsas məqsədi biologiya və genetika sahəsində təhsil alan tələbələrin klinik laboratoriya biliklərini artırmaq, onları müasir diaqnostik metodlarla tanış etmək və praktiki bacarıqlarını inkişaf etdirmək olub.